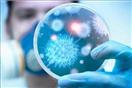

"غير صحيح".. خبير فيروسات تعليقًا على دراسة فرنسية حول تأثير النيكوتين على كورونا
كتب- حسن مرسي:
كتب- حسن مرسي:
عقب الدكتور عادل خطاب، أستاذ الأمراض الصدرية بطب عين شمس وعضو اللجنة العليا لأبحاث الفيروسات، على دراسة نشرها باحثون فرنسيون حول تأثير النيكوتين في علاج فيروس الكورونا وأن المدخنين أقل عرضة للإصابة بعدوى كورونا، قائلًا: "كلام غير صحيح وغير علمي".
وأضاف خطاب، في مداخلة هاتفية مع الإعلامي عمرو أديب، ببرنامج "الحكاية"، المُذاع عبر فضائية "mbc مصر"، مساء السبت، أن السلطات الصحية الفرنسية لم توافق حتى الآن على تلك الأبحاث، لافتًا إلى أن هناك عشرات من الأبحاث والدراسات الواقعية التي تم توثيقها على حالات مصابة بفيروس كورونا تؤكد خطأ تلك الدراسة.
وأكد أستاذ الأمراض الصدرية بطب عين شمس، أن 10% من الحالات الخطيرة لمصابي كورونا من مرضى القلب المرتبطة بالتدخين، وهناك دراسة أكدت أن الأمراض التنفسية في الرئة مرتبطة بتلك العادة السيئة.





















